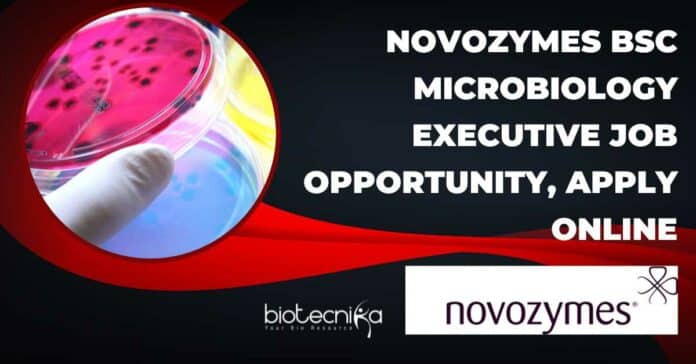

Novozymes BSc Microbiology Executive Job Opportunity, Apply Online
Novozymes BSc Microbiology Executive Job Opportunity, Apply Online. BSc Microbiology candidates are encouraged to apply for an Executive Microbiology vacancy at Novozymes. Interested and eligible applicants can check out all of the details on the same below
Hey, if you are wondering what type of interview questions can be asked for the role of EXECUTIVE MICROBIOLOGY at Novozymes, then take a look below, these are just some possibilities but can help you base your preparation on them.
Name of the Post – EXECUTIVE MICROBIOLOGY
Location – Bangalore
Reference No – 11235BR
Job Area – Production
Rethink your impact
Are you passionate about Microbiology? Then you might be our new Executive Microbiology
Work for a cause, not just a company
Novozymes is the world’s leading provider of industrial enzymes and microorganisms. Together with our customers, partners, and the global community, we use our innovative thinking and passion for science to boost industries and make everyday products more sustainable for the good of the planet. Our biological solutions enable higher agricultural yields, healthy food consumption, low-temperature washing, energy-efficient production, renewable fuel, and many other biological solutions that the world can benefit from – both today and in years to come. We need people who are eager to try new things, motivated by challenge, and not afraid to fail but driven to try again. And again. We know that original thinking happens when we’re given the flexibility to focus and the freedom to fully unfold our individual strengths. This is key to our innovation power. We call it Rethink Tomorrow.
Join us as our new Executive Formulation department
- We produce nutraceuticals as dietary ingredients catering to supplements and the pharma industry.
- Site has manufacturing and bulk formulation capabilities.
- Candidate should be self-motivating and a team player in in-process production laboratory.
- Reporting will be to Fermentation and Microbiology InCharge.
Welcome to Operations
- Dynamic production capability with a high throughput of products.
- In-process production analysis is key to delivering timely inputs for production batches.
- This role requires coordination between the fermentation team, recovery team and QC team.
In this role you’ll make an impact by:
- Performing microbiological analysis of samples from different stages of production.
- Maintain documentation as per quality requirements.
- Prepare trends of analysis, to support external audits.
Potentially relevant experience:
- Bachelor of Microbiology or Pharmacy with knowledge of microbiology.
- Minimum 1-2 years of experience.
- Should have sound knowledge of Microbiology techniques and lab instruments.
- Good communication skills.
- Should be a quick learner and ready to take responsibility.
Location –
This job will be located at Synergia Life Sciences Pvt. ltd. (Now a part of Novozymes) Wada, Dist. Palghar, Maharashtra.
Are you passionate about making a sustainable impact, and do you see yourself in this position? Then unlock your passion and apply today!
Application Deadline – 30/05/2023
Hey, if you are wondering what type of interview questions can be asked for the role of EXECUTIVE MICROBIOLOGY at Novozymes, then take a look below, these are just some possibilities but can help you base your preparation on them.
- Can you describe your experience in performing microbiological analysis in a production or laboratory setting?
- Answer: I have a Bachelor’s degree in Microbiology and have been working in a production laboratory for the past two years. My experience includes conducting microbiological analysis of samples at different stages of production, following standard protocols, and ensuring accurate documentation of results.
- How do you ensure compliance with quality requirements and maintain documentation in a microbiology laboratory?
- Answer: I understand the importance of maintaining high-quality standards in a microbiology laboratory. I adhere to documented procedures, conduct regular calibrations of lab instruments, implement quality control measures, and maintain accurate records of analysis results to ensure compliance with quality requirements.
- Have you participated in external audits? If yes, can you explain your role in preparing trends of analysis to support the audits?
- Answer: Yes, I have participated in external audits during my previous employment. As part of the audit preparation, I have compiled and analyzed trends of analysis data, highlighting any deviations or trends that required attention. This information was used to demonstrate the effectiveness of our microbiological processes and support the audit findings.
- How do you coordinate with different teams, such as fermentation, recovery, and quality control, to ensure smooth operations and timely delivery of inputs for production batches?
- Answer: Collaboration and effective communication are essential in coordinating with different teams. I actively engage with the fermentation team to understand their requirements and provide timely analysis inputs. I coordinate with the recovery team to ensure proper handling of samples, and I work closely with the quality control team to address any deviations or quality concerns that may arise during the process.
- Can you provide an example of a challenging situation you encountered in a microbiology laboratory and how you resolved it?
- Answer: In a previous role, we encountered a contamination issue in one of the production batches. I promptly conducted a thorough investigation, which involved extensive sampling and microbial analysis. By identifying the source of contamination and implementing corrective measures, we were able to prevent further incidents and ensure the production of high-quality batches.
Remember, these are sample interview questions and answers based on the provided job description. It’s essential to personalize your responses and provide specific examples from your own experiences and knowledge.
Editor’s Note: Novozymes BSc Microbiology Executive Job Opportunity, Apply Online. Please ensure that you are subscribed to the Biotecnika Times Newsletter and our YouTube channel to be notified of the latest industry news. Follow us on social media like Twitter, Telegram, Facebook